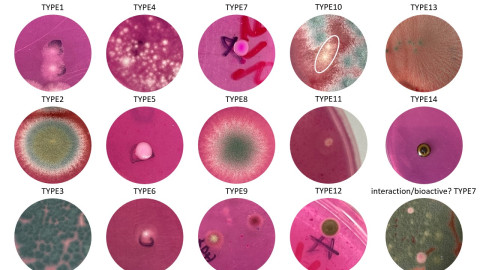
Marine fungi

This project is a collaboration between researchers from Victoria University of Wellington and Kōrero O Te `Ōrau, an environmental Non-Governmental Organisation (NGO) in the Cook Islands.
New antimicrobials are needed to help against the antimicrobial resistance crisis. Antimicrobial resistance occurs when microorganisms that cause infection - bacteria, viruses, fungi, and parasites - lose their susceptibility to drugs. This complicates the treatment of infections, increases the likelihood of disease transmission, and leads to potentially severe outcomes following routine medical procedures such as surgery.
The problem has risen to dangerously high levels globally and poses a significant threat to human health. This is especially concerning for Māori and Pacific peoples, who are already disproportionately impacted by infectious and non-communicable diseases.
Research is now looking to the oceans for natural products with therapeutic effects to treat infection. However, South Pacific marine microbial natural products are yet to be investigated.
Pacific peoples have a rich history of utilising natural remedies, and there is a growing recognition of the therapeutic potential of natural products from microbesand plants. By incorporating Cook Islands Indigenous knowledge with science, the research aims to unlock the medicinal potential of Cook Islands marine-microbes and potentially expand the repertoire of available antimicrobial medicines.
Studies have shown microbes like bacteria and fungi that live on host macro-organisms such as sponges or seaweeds produce natural chemicals that prevent the growth of harmful microbes and pathogenic disease. These marine microbes may therefore be a treasure trove of unique compounds with antimicrobial activity.
This project combines Pacific-led scientific innovation and Pacific Indigenous wisdom.
As the research involves Cook Islands knowledge and samples collected from Cook Islands ‘enua (land), ownership and governance of generated genomic data and any associated IP will belong to the Cook Islands and its people.
Project outcomes include:
- Strengthening collaborative relationships between researchers and the Cook Islands community, particularly Kōrero O Te `Ōrau, but also with iti tangata partners and traditional knowledge holders;
- Contributing to Cook Islands Indigenous knowledge, utilising traditional knowledge and augmenting this knowledge through complementary scientific aspects;
- Potential training opportunities through fostering STEM pathways for Pasifika students;
- Generating preliminary results from which to seek further contestable funding;
- Research dissemination to Pasifika communities in the Cook Islands and in Aotearoa.
Team
- Dr V. Helen Woolner, Victoria University of Wellington
- Dr Jeremy G. Owen, Victoria University of Wellington
- Dr Teina Rongo, Kōrero O Te `Ōrau, Rarotonga